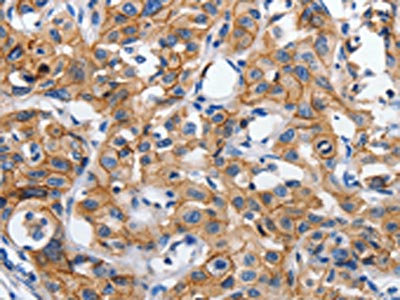

-
中文名稱:CDH1兔多克隆抗體
-
貨號:CSB-PA218378
-
規格:¥1100
-
圖片:
-
The image on the left is immunohistochemistry of paraffin-embedded Human cervical cancer tissue using CSB-PA218378(CDH1 Antibody) at dilution 1/100, on the right is treated with synthetic peptide. (Original magnification: ×200)
-
The image on the left is immunohistochemistry of paraffin-embedded Human lung cancer tissue using CSB-PA218378(CDH1 Antibody) at dilution 1/100, on the right is treated with synthetic peptide. (Original magnification: ×200)
-
Gel: 8%SDS-PAGE, Lysate: 40 μg, Lane 1-3: Human brain malignant glioma tissue, Human colon cancer tissue, mouse pancreas tissue, Primary antibody: CSB-PA218378(CDH1 Antibody) at dilution 1/1950, Secondary antibody: Goat anti rabbit IgG at 1/8000 dilution, Exposure time: 3 seconds
-
-
其他:
產品詳情
-
Uniprot No.:
-
基因名:
-
別名:Arc 1 antibody; CADH1_HUMAN antibody; Cadherin 1 antibody; cadherin 1 type 1 E-cadherin antibody; Cadherin-1 antibody; Cadherin1 antibody; CAM 120/80 antibody; CD 324 antibody; CD324 antibody; CD324 antigen antibody; cdh1 antibody; CDHE antibody; E-Cad/CTF3 antibody; E-cadherin antibody; ECAD antibody; Epithelial cadherin antibody; epithelial calcium dependant adhesion protein antibody; LCAM antibody; Liver cell adhesion molecule antibody; UVO antibody; Uvomorulin antibody
-
宿主:Rabbit
-
反應種屬:Human,Mouse,Rat
-
免疫原:Synthetic peptide of Human CDH1
-
免疫原種屬:Homo sapiens (Human)
-
標記方式:Non-conjugated
-
抗體亞型:IgG
-
純化方式:Antigen affinity purification
-
濃度:It differs from different batches. Please contact us to confirm it.
-
保存緩沖液:-20°C, pH7.4 PBS, 0.05% NaN3, 40% Glycerol
-
產品提供形式:Liquid
-
應用范圍:ELISA,WB,IHC
-
推薦稀釋比:
Application Recommended Dilution ELISA 1:2000-1:10000 WB 1:1000-1:5000 IHC 1:50-1:200 -
Protocols:
-
儲存條件:Upon receipt, store at -20°C or -80°C. Avoid repeated freeze.
-
貨期:Basically, we can dispatch the products out in 1-3 working days after receiving your orders. Delivery time maybe differs from different purchasing way or location, please kindly consult your local distributors for specific delivery time.
-
用途:For Research Use Only. Not for use in diagnostic or therapeutic procedures.
引用文獻
- Circular RNA pyridoxal kinase (circPDXK) involves in the progression of ovarian cancer and glycolysis via regulating miR-654-3p and hexokinase II L Hou,Applied Biological Chemistry,2022
相關產品
靶點詳情
-
功能:Cadherins are calcium-dependent cell adhesion proteins. They preferentially interact with themselves in a homophilic manner in connecting cells; cadherins may thus contribute to the sorting of heterogeneous cell types. CDH1 is involved in mechanisms regulating cell-cell adhesions, mobility and proliferation of epithelial cells. Has a potent invasive suppressor role. It is a ligand for integrin alpha-E/beta-7.; E-Cad/CTF2 promotes non-amyloidogenic degradation of Abeta precursors. Has a strong inhibitory effect on APP C99 and C83 production.; (Microbial infection) Serves as a receptor for Listeria monocytogenes; internalin A (InlA) binds to this protein and promotes uptake of the bacteria.
-
基因功能參考文獻:
- pathogenic variants are described in four genes encoding components of the p120-catenin complex (CTNND1, PLEKHA7, PLEKHA5) and an epithelial splicing regulator (ESRP2), in addition to the known Cleft lip/Palate-associated gene, CDH1, which encodes E-cadherin. PMID: 29805042
- NEDD9, E-cadherin and gamma-catenin proteins have roles in pancreatic ductal adenocarcinoma PMID: 29924959
- detection of Ezrin and E-cadherin expression in cervical smears, could be a potential prognostic marker for identifying cervical lesions with high-risk of progression to invasive cervical cancer, and may help on the selection of an appropriate therapy or avoid unnecessary treatment PMID: 29587669
- CDH1 plays an essential role in epithelial cell adherence. Causative of blepharocheilodontic syndrome CDH1 mutations impair the cell adhesion function of the cadherin-catenin complex in a dominant-negative manner. PMID: 29348693
- Together, these data suggest that the S18-2 protein induces epithelial to mesenchymal cell transition through the TWIST2/E-cadherin signalling and, consequently, CXCR4-mediated migration of prostate cancer cells. PMID: 29396484
- In the present study, we demonstrated that miR711mediated downregulation of CD44 expression inhibited EMT of gastric cancer cells in vitro and in vivo by downregulating vimentin protein expression and upregulating Ecadherin protein expression through transfection, qRTPCR and western blotting PMID: 30226620
- Soluble E-cadherin (sE-cad) (an 80-kDa soluble form), which is highly expressed in the malignant ascites of ovarian cancer patients, is a potent inducer of angiogenesis. In addition to ectodomain shedding, we provide further evidence that sE-cad is abundantly released in the form of exosomes. PMID: 29891938
- In the former, p53 binds to the CDH1 (encoding E-cadherin) locus to antagonize EZH2-mediated H3K27 trimethylation (H3K27me3) to maintain high levels of acetylation of H3K27 (H3K27ac). PMID: 29371630
- E-cadherin silencing relies on the formation of a complex between the paRNA and microRNA-guided Argonaute 1 that, together, recruit SUV39H1 and induce repressive chromatin modifications in the gene promoter PMID: 28555645
- The results show how E-cadherin instructs the assembly of the LGN/NuMA complex at cell-cell contacts, and define a mechanism that couples cell division orientation to intercellular adhesion. PMID: 28045117
- Low CDH1 expression is associated with pancreatic cancer. PMID: 29956814
- the dysregulation of TET2/E-cadherin/beta-catenin regulatory loop is a critical oncogenic event in HCC progression PMID: 29331390
- At the molecular level, transcription of the adherens junction protein E-cadherin is upregulated on nicotinic acid addition, leading to accumulation of E-cadherin protein at the cell-cell boundary. This can be attributed to nicotinic acid's ability to facilitate the ubiquitination and degradation of Snail1, a transcription factor that represses E-cadherin expression. PMID: 28256591
- down-regulation of USP48 increases E-cadherin expression and epithelial barrier integrity through reducing TRAF2 stability PMID: 28874458
- AnxA5 2D-network mediates E-cadherin mobility in the plasmalemma that triggers human trophoblasts aggregation and thereby cell fusion. PMID: 28176826
- The disassociation of the beta-catenin/E-cadherin complex in the osteoblast membrane under stretch loading and the subsequent translocation of beta-catenin into the nucleus may be an intrinsic mechanical signal transduction mechanism. PMID: 29901167
- The presence of E-cadherin decreases cortical contractility during mitosis through a signaling cascade leading to multipolar divisions, and its knockout promotes clustering and survival of cells with multiple centrosomes. PMID: 29133484
- E-cadherin expression is not significantly linked to metastatic disease in pancreatic ductal adenocarcinoma. PMID: 29355490
- High CDH1 expression is associated with the Pathogenesis of Adamantinomatous Craniopharyngiomas. PMID: 29625497
- study provides evidence for genetic polymorphisms of the adherent junction component cadherin gene and the association of its haplotypes with leukoaraiosis PMID: 30017735
- found that E-cadherin, N-cadherin and fibronetin are involved in CHD4-mediated epithelial-mesenchymal transition PMID: 29305962
- Up-regulation of H19 in bladder cancer tissues is correlated with clinical stage or metastasis of cancer. By cell transfection to suppress H19 expression in bladder cancer cells, E-cadherin expression is up-regulated, thus weakening metastatic potency of cancer cells. PMID: 29614625
- These findings suggested that PHF8 played an oncogenic role in facilitating FIP200-dependent autophagic degradation of E-cadherin, EMT and metastasis in hepatocellular carcinoma (HCC). PHF8 might be a promising target for prevention, treatment and prognostic prediction of HCC. PMID: 30180906
- When ANXA5 expression increased, cell proliferation was inhibited by regulating the expression of bcl-2 and bax while cell metastasis was suppressed by regulating E-cadherin and MMP-9 expression. PMID: 30010106
- Six2 is negatively correlated with good prognosis and decreases 5-FU sensitivity via suppressing E-cadherin expression in HCC cells. PMID: 29772441
- The - 73A > C CDH1 promoter variation may lead to differences in the overall survival of sporadic gastric carcinoma patients and allele-specific repressions of CDH1. PMID: 29168119
- Overexpression of KLF6-SV1 is associated with young patients, and loss of E-cadherin suggests that this variant correlated with the aggressiveness of nasopharyngeal carcinoma. PMID: 29854578
- Smad4 could be considered as a central component of EMT transition in human colorectal cancer that combines with transcriptional factors to reduce E-cadherin and alter the expression of the epithelial phenotype. PMID: 29468299
- hnRNP H/F are important for maintenance and differentiation of embryonic stem cells and that this at least in part reflects a switch in TCF3 alternative splicing that leads to repression of CDH1/E-cadherin. PMID: 30115631
- E-Cadherin and epithelial syndecan-1 were more highly expressed in intraluminal/luminal unicystic ameloblastoma than in mural unicystic ameloblastoma and solid/multicystic ameloblastoma, whereas the stromal expression of syndecan-1 was higher in mural unicystic ameloblastoma and solid/multicystic ameloblastoma. PMID: 29850393
- miR-219-5p promotes tumor growth and metastasis of HCC by regulating CDH1 and can serve as a prognostic marker for HCC patients. PMID: 29862272
- Plasma sE-cadherin levels and sE-cadherin/sVE-cadherin ratios are potential biomarkers for COPD. PMID: 29376431
- the HDAC inhibitors augmented both Ecadherin and vimentin expression and their effects varied in different cholangiocarcinoma cell lines. Therefore, the clinical use of HDAC inhibitors in biliary cancer should be considered cautiously PMID: 29767267
- E-cadherin expression was preserved in 10 (21.28%) of the 47 NSCLCs immunostained with anti-E-cadherin antibody and reduced/absent in 37 of the 47 (78.72%) NSCLCs studied. E-cadherin plays a major role in the intercellular adhesion. PMID: 29556623
- CDH1 promoter methylation may be correlated with cervical cancer carcinogenesis, especially for Caucasians. It was associated with histological subtypes PMID: 29237293
- High UTX expression is independently associated with a better prognosis in patients with esophageal squamous cell carcinoma (ESCC) and downregulation of UTX increases ESCC cell growth and decreases E-cadherin expression. Our results suggest that UTX may be a novel therapeutic target for patients with ESCC. PMID: 29351209
- Data suggest that ECAD, STAT3, Bak, and Bcl-xL are expressed in affected endometrial tissues of women with endometrioid adenocarcinoma depending on neoplasm staging and cell differentiation. This study was conducted using immunohistochemistry of surgically resected tissues. (STAT3 = signal transducer and activator of transcription 3 protein; Bak = pro-apoptotic protein BAK; Bcl-xL = BCL2 associated agonist of cell death) PMID: 28937296
- LncRNA RP11-789C1.1 inhibited EMT in GC through the RP11-789C1.1/miR-5003/E-cadherin axis, which could be a promising therapeutic target for Gastric Cancer. PMID: 29991048
- Using single-molecule localization microscopy, we show that pAJs in these cells reach more than 1 mum in length and consist of several cadherin clusters with crystal-like density interspersed within sparser cadherin regions. Notably, extrajunctional cadherin appears to be monomeric, and its density is almost four orders of magnitude less than observed in the pAJ regions. PMID: 29691319
- CDH1 methylation may play a role in the initiation and progression of salivary carcinoma ex pleomorphic adenoma PMID: 29207084
- We illustrate the approach using immunohistochemical measurements of the epithelial-mesenchymal transition marker E-cadherin in a set of colorectal primary tumors from a population-based prospective cohort in North Carolina PMID: 29338703
- The aim of our study was to analyze the immunohistochemical expression of beta-catenin, E-cadherin and Snail, depending on clinico-morphological aspects of the laryngeal squamous cell carcinomas. Results revealed variable E-cadherin, beta-catenin and Snail expression, depending on differentiation degree and tumor stage. PMID: 29250652
- Twist, E-cadherin, and N-cadherin protein were differently expressed in endometrioid adenocarcinoma tissues and in normal endometrium which indicates their potential function for endometrioid adenocarcinoma development. PMID: 29237910
- Findings uncover a new regulatory network in RCC involving metastasis-promoting miR-720 that directly targets expression of key metastasis-suppressing proteins E-cadherin and alphaE-catenin complex. PMID: 28802251
- Results show that E-cadherin expression levels were negatively regulated by 90K via ubiquitination-mediated proteasomal degradation in a cell density-dependent manner. PMID: 29207493
- these results indicate that increased alpha-actinin-1 expression destabilizes E-cadherin-based adhesions, which is likely to promote the migratory potential of breast cancer cells. Furthermore, our results identify a-actinin-1 as a candidate prognostic biomarker in basal-like breast cancer. PMID: 29742177
- High glucose enhances the formation of EZH2/Snail/HDAC1 complex in the nucleus, which in turn causes E-cadherin repression. PMID: 29705809
- TGF-beta1 induced epithelial-mesenchymal transition in non-small cell lung cancer cells by upregulating miR-9 and downregulating miR-9's target, E-cadherin. PMID: 29118814
- Results show that E-cadherin/beta-catenin complex is disrupted by ICAT promoting epithelial-mesenchymal transition of cervical cancer cells. . PMID: 29048651
- Studies categorize cadherin 1 (CDH1) variants, as neutral or deleterious. PMID: 29231860
顯示更多
收起更多
-
相關疾病:Hereditary diffuse gastric cancer (HDGC); Endometrial cancer (ENDMC); Ovarian cancer (OC); Breast cancer, lobular (LBC); Blepharocheilodontic syndrome 1 (BCDS1)
-
亞細胞定位:Cell junction, adherens junction. Cell membrane; Single-pass type I membrane protein. Endosome. Golgi apparatus, trans-Golgi network. Note=Colocalizes with DLGAP5 at sites of cell-cell contact in intestinal epithelial cells. Anchored to actin microfilaments through association with alpha-, beta- and gamma-catenin. Sequential proteolysis induced by apoptosis or calcium influx, results in translocation from sites of cell-cell contact to the cytoplasm. Colocalizes with RAB11A endosomes during its transport from the Golgi apparatus to the plasma membrane.
-
組織特異性:Non-neural epithelial tissues.
-
數據庫鏈接:
Most popular with customers
-
-
YWHAB Recombinant Monoclonal Antibody
Applications: ELISA, WB, IHC, IF, FC
Species Reactivity: Human, Mouse, Rat
-
Phospho-YAP1 (S127) Recombinant Monoclonal Antibody
Applications: ELISA, WB, IHC
Species Reactivity: Human
-
-
-
-
-